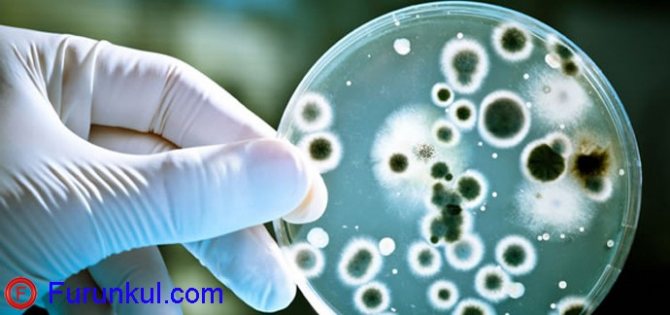
image
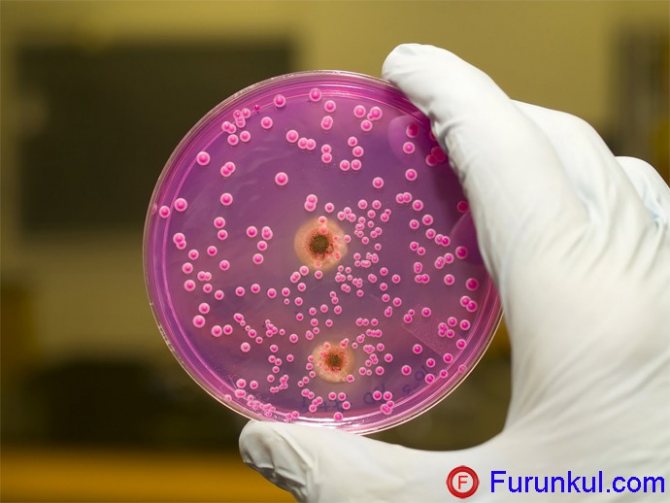
image

Происхождение болезни
Причиной возникновения фурункулеза является стафилококк золотистый, но в некоторых случаях болезнь могут спровоцировать бактерии стафилококка другого вида –эпидермального. Обе бактерии присутствуют в окружающей среде. 70% людей на планете являются их носителями.
Микроорганизмы могут переходить от зараженного человека к другим людям, но на совершенно здоровом болезнь не развивается, так как для этого нужны дополнительные благоприятные для бактерий факторы. Проще говоря, для заражения фурункулезом не так важен патогенный микроорганизм, как факторы, способствующие его размножению. Такие факторы могут быть внешними и внутренними.
Чаще всего основной причиной возникновения болезни является ослабленный иммунитет у человека. Внешние причины могут быть такими: травмы эпидермиса, дерматологические патологии, а внутренние факторы (внутренние причины) – это:
- снижение иммунитета;
- хронические заболевания;
- витаминный дефицит;
- аутоиммунные расстройства (диабет);
- избыточный вес;
- болезни системы ЖКТ;
- анемия;
- патологии нервной системы.
Причины
Вызвать заболевание может обычная травма кожных покровов или их расчесывание. Фурункулы часто являются результатом несоблюдения элементарных норм личной гигиены. Наиболее вероятной причиной появления чирей является ослабленный иммунитет, возникающий на фоне таких заболеваний, как:
- сахарный диабет;
- болезни ЖКТ;
- алкоголизм;
- заболевания нервной системы;
- проблемы с эндокринной системой;
- малокровие;
- частые переохлаждения и перегревания;
- гиповитаминозы.
Обычно заболевание возникает весной, когда организм испытывает недостаток в витаминах и микроэлементах.
Данное заболевание опасно еще тем, что им можно заразиться от другого человека. Избежать этого поможет знание основных симптомов недомогания. Вовремя обнаруженная болезнь и своевременно назначенное лечение станет гарантией здоровья других членов семьи и всех окружающих.
Этапы развития
Фурункулез представляет собой гнойничковое местное воспаление с образованием обширного уплотнения – инфильтрата. Фурункулы образуются в волосяных фолликулах, сальных железах и в жировой ткани, которая находится под кожным покровом у человека.
При наличии благоприятных факторов бактерии-возбудители начинают активно размножаться, питаться и выделять отходы, чем и провоцируют развитие гнойного процесса. Фурункул проходит определенные стадии развития до прорыва капсулы с гноем, из которой затем выходит гнойный стержень:
- На начальной стадии образуется небольшой узел в основании волосяного фолликула.
- Через несколько дней на месте узла вырастает конусообразный чирей с некротическим образованием в центральной части.
- Вместе с фолликулом поражаются сальные железы и прилегающие слои кожи. Созревшее образование вызывает сильный отек тканей и может сопровождаться болезненностью.
- Затем гнойный очаг вскрывается, из него выходят гнойные массы в обильном количестве, а в очистившейся ране формируется язва со стержнем зеленоватого оттенка.
- В итоге стержень выходит вместе с остатками гноя и кровью, после чего болезненные ощущения утихают.
Этот процесс достаточно длительный и доставляет массу дискомфортных ощущений. При особо тяжелых формах фурункулеза образуются карбункулы – скопления гнойных очагов. Лечить болезнь желательно медикаментами после консультации с дерматологом, но также можно практиковать лечение народными средствами.
Симптомы
Фурункулы появляются чаще всего на пояснице, затылке, ягодицах и животе. Хотя нет гарантии, что исключением станет лицо, шея, руки и ноги. Единственные места, на которых не могут образовываться чири, это ладони рук и подошвы. Объясняется этот факт тем, что там нет волосяных фолликулов. Образование фурункула происходит так:
- Появляется небольшое уплотнение около волосяного фолликула. Оно болезненное, чувствуется боль, по цвету — темно-красное с синюшным оттенком.
- Опухоль становится ярко выраженной, размеры ее увеличиваются.
- Если фурункул на лице, то возможна отечность щек, губ или век.
- Спустя 4 дня, фурункул становиться конусообразным, хорошо виден гнойный стержень. Его вершина — это желтая точка, которая носит название пустула.
- Происходит повышение температуры, возникает общее недомогание и головная боль.
- Верхушка фурункула вскрывается, это может произойти и без лечения. Иногда происходит выделение гноя с кровью.
- Стержень отторгается, боли проходят, а оставшийся кратер затягивается на протяжении нескольких дней.
Длительность излечения составляет до 10 дней.
Иногда заболевание протекает почти незаметно, что особенно опасно. Человек, не подозревая о своем недомогании, может стать источником заражения для остальных.
В этом случае нет нагноения, стержень фурункула почти незаметен. Такая ситуация характерна для людей с ослабленным иммунитетом.
Высокая температура часто сопровождает созревание фурункула
Заразен ли фурункул для окружающих
Так как чирей служит очагом бактериальной инфекции и источником вредных агентов, то он безусловно заразен. Но подхватить эту болезнь без наличия дополнительных благоприятных факторов невозможно. Точнее, можно подцепить бактерию, особенно через контакт с гноем и кровью из чирья, но она не разовьется в здоровом организме настолько, чтобы спровоцировать инфекцию.
Даже если контактировать тесно с нарывом другого человека, заражение не произойдет. Передача невозможна даже при половых контактах с партнером, у которого присутствуют фурункулы на интимных органах, если нет к этому предрасположенности. Следовательно, ответить на вопрос, заразный или нет фурункулез, можно так: сама болезнь нет, а ее возбудитель – да.
Передается ли от матери к ребенку
Зная, как передается заболевание, логично будет спросить: заразно ли оно для ребенка при контакте с матерью, если у нее есть чирьи? Как известно, дети, особенно грудные, очень слабы и имеют еще не до конца сформированный иммунитет, а значит, у них есть предрасполагающие факторы к заражению.

Залогом нормального, правильного развития грудных детей является материнское молоко. Поэтому переставать кормить ребенка при наличии вышеописанной проблемы не стоит.
Можно ли заразиться фурункулами при половом контакте
Половым путем могут передаваться бактерии, также существует вероятность попадания гноя в ранки на слизистых, что может спровоцировать воспаление. Но сам фурункулез таким образом не передается, так как для его развития нужны более серьезные причины, а именно совокупность неблагоприятных факторов.
Если человек здоровый, то передача именно чирьев от больного здоровому невозможна, даже если они расположены в интимной зоне. Но не стоит забывать, что есть еще и другие, более серьезные инфекции и ЗППП (болезни, передающиеся половым путем), поэтому предохраняться во время половых контактов нужно обязательно.
Риск заражения в медицинской и косметологической клинике
Многие волнуются, можно ли подцепить фурункул в клиниках, например, у косметолога или дерматолога. Ответ категоричен: нет, так как все инструменты перед использованием и после косметологических или медицинских процедур проходят тщательную дезинфекцию, поэтому передаваться через них ничего не должно. Такая обработка уничтожает не только стафилококк, но и более опасные бактерии, вирусы, грибки.
Но если воспользоваться услугами косметолога на дому или в малоизвестном салоне, где инструменты не обрабатываются вообще или обрабатываются неправильно, тогда можно подцепить не только стафилококк.
Можно ли заразиться в бане или бассейне от другого человека
Фурункулез заразен или нет: как передается человека к человеку
Фурункулез – это заболевание, которое возникает при появлении сразу нескольких очагов гнойно-воспалительного процесса. Развитие происходит в волосяных мешочках и, чаще всего, вызвано стафилококками.
Размер фурункула может быть разным – от небольшой горошинки до 1,5 см в диаметре.
Часто назначаются антибиотики при фурункулезе, так как из-за особенностей расположения очагов, существует вероятность попадания воспаления в кровоток.
Замечают недуг обычно в области шеи, подмышек, лица, паха и ягодиц. Обнаружить у себя появление такой болезни несложно – большой прыщ с заметным гнойным содержимым указывает на то, что необходимо срочно посетить дерматолога.
Причины фурункулеза
Основной причиной заболевания является стафилококк, но при нормальной работе иммунитета и отсутствии провоцирующих факторов развитие фурункулеза не произойдет. Воспаление происходит при попадании в волосяную луковицу бактерий. Спровоцировать недуг могут следующие ситуации:
- Небольшое нарушение целостности кожи – при ссадинах и царапинах под кожу и в волосяные луковицы может попасть инфекция.
- Несоблюдение личной гигиены, чрезмерное загрязнение кожи.
- Наличие хронических заболеваний, которые приводят к снижению иммунитета.
- Контактирование кожи с патологическими выделениями, которые возникают при воспалительных инфекционных заболеваниях.
- Регулярное контактирование с вредными веществами, строительным мусором, пылью.
- Нарушение работы гормонального фона человека.
- Вросшие волоски на теле могут спровоцировать попадание инфекции.
- Переутомление и стрессы.
При возникновении фурункулеза выявляются причины, и лечение назначается врачом. Это необходимо для того, чтобы избежать распространения очагов и серьезных осложнений.
Симптомы и стадии болезни
Фурункул развивается постепенно, весь цикл состоит из трех фаз, для каждой из которых характерны свои признаки. Стадии болезни следующие:
- Инфильтрат. На месте очага инфекции возникает отек, кожа уплотняется и заметно краснеет. При нажатии возникает сильная боль, а в центре воспаления виден волосяной фолликул. Стадия длится не более 3-4 суток.
- Некроз. Вокруг воспаленного волосяного фолликула возникает определенный стержень, который состоит из гноя и отмерших тканей. На месте красного уплотнения появляется хорошо заметный белый гнойник, после чего кожа над ним лопается и гной выходит. Спадает отек и покраснение, человек чувствует заметное облегчение, боль уменьшается.
- Заживление. Происходит образование небольшой язвы, которая постепенно заживает. В большинстве случаев, на месте фурункулов остаются небольшие рубцы, которые не проходят со временем.
С первых признаков до образования рубца проходит не менее 10 суток, однако при больших размерах фурункулов заживление может длиться дольше. Важно помнить, что вскрытие происходит самостоятельно или при участии врача. Фурункулез часто возникает при выдавливании или прокалывании воспаления в домашних условиях, что приводит к разрастанию очагов воспаления.
https://youtube.com/watch?v=lJAhNKJhXSk
Заметить у себя фурункул легко благодаря характерным особенностям. Кроме проявлений фурункулеза, заметных на фото, которые описаны в стадиях болезни, есть еще и другие признаки, сопровождающие патологию. Например, общее недомогание, слабость, повышение температуры тела.
В некоторых случаях человек думает, что простыл и начинает лечиться от этого заболевания. Обратиться к специалисту стоит, если появились следующие симптомы:
- онемение участка кожи, появление боли, зуда, покраснения;
- плохое самочувствие, повышенная температура тела;
- тошнота, отсутствие аппетита, бессонница;
- очаг воспаления находится в области носогубного треугольника, паха или в районе бровей;
- пораженный участок становится синюшного оттенка.
Желательно проконсультироваться с доктором, если фурункулы появляются часто или одновременно в нескольких местах.
Виды фурункулов
Появление фурункула возможно в любой части тела, за исключением ладоней и стоп. Существует несколько видов этого недуга, которые отличаются между собой местом локализации и симптомами. Все виды представлены в таблице:
| Фурункул обычный | Проявляется в виде одиночного очага, воспаление происходит в одном волосяном фолликуле |
| Карбункул | Более тяжелая форма, при которой одновременно воспаляется несколько фолликулов, расположенных рядом. Фурункулы сливаются, образуя обширное воспаление на коже. Вскрытие происходит достаточно тяжело, так как гной выходит сразу в нескольких местах. Такой вид гораздо опаснее, поэтому лечение должно происходить под контролем врача |
| Кистозная угревая форма | В этом случае воспаление возникает не на поверхности, а в глубоких слоях ткани. Часто встречается у людей с гормональными сбоями и в период полового созревания. На стандартный фурункул этот вид не очень похож, поэтому нередко остается без внимания. При отсутствии лечения остаются очень заметные шрамы |
| Пилонидальный синус | Этот вид локализуется между ягодицами. Доставляет сильнейший дискомфорт, при этом есть опасность его распространения при выходе гноя. Обращение к врачу обязательно |
| Гнойный гидраденит | Воспаление потовых желез, которое проявляется в виде множества кожных нарывов, не имеющих стержня. Требуют обязательного удаления хирургическим путем, как можно раньше. Обычно возникает в подмышечной впадине и в области паха |
По расположению и внешнему виду фурункула можно самостоятельно определить, к какому виду он относится. Если возникают сомнения или воспаление доставляет сильный дискомфорт – следует посетить врача, который назначит правильное лечение.
Лечение
Перед тем как лечить фурункулез, необходимо обратиться к врачу. Независимо от того, какой способ выберет человек – медикаментозный или народные средства, необходимо исключить вероятность осложнений. Однократно вылечив фурункул нельзя быть уверенным, что он не появится снова, поэтому подходить к этому следует ответственно.
Народные средства
Многие не любят посещать поликлиники, поэтому пытаются лечиться при помощи народных средств. Это не всегда возможно, так как иногда вылечить фурункулез в домашних условиях не выйдет, можно добиться лишь осложнений. Если, несмотря на опасность, решено лечиться самостоятельно без применения лекарств, можно воспользоваться одним из следующих рецептов:
- Хозяйственное мыло с молоком. В небольшую металлическую миску (лучше чашку) натереть мыло, чтобы оно закрывало дно, после чего налить молока в пропорции 1:2. В течение часа нагревать на водяной бане, чтобы получилась мазь, по консистенции как сметана. Ежедневно накладывать смесь на фурункул на 6 часов под повязку, до полного исчезновения воспаления.
- Алоэ. Хороший способ, особенно если применять его начала нарывания фурункула, то есть до момента образования гноя. Помыв лист и обрезав колючки, необходимо немного порубить его ножом. После этого привязать к воспалению на 4 часа, после снятия сразу повторить процедуру.
- Уменьшить фурункулез, то есть частоту появления воспалений, можно очистив кровь. Для этого необходимо промыть корни одуванчика, положить в стакан 1 ч.л. и залить стаканом кипятка. Настой будет готов через 3 часа, принимать необходимо 6 раз в день по 1 ст.л.
- Печеный лук. Луковицу разрезать на 4 части и запекать в духовке около получаса. После этого приложить к воспалению разрезом и привязать на сутки. Более эффективный метод – растереть в кашицу лук и смешать с натертым хозяйственным мылом, в пропорции 2:1. Прикладывается полученная мазь также на сутки, после чего меняется, если не произошел выход гноя.
Эти способы рекомендуется использовать только в случаях, когда гноя еще нет, и фурункул находится на начальной стадии. Следует учитывать, что все гнойники выше уровня плеч лечатся только врачом и строго под его контролем. Самолечение в этой ситуации может стоить человеку жизни.
Терапия фурункулов
Первым делом нужно пойти в больницу к дерматологу и найти точную причину фурункулеза. Лечить чирьи самостоятельно не рекомендуется, так как без устранения причины болезнь не исчезнет и в скором времени даст рецидив. Вскрывать фурункулы в домашних условиях тоже нельзя, так как гной и некротическая ткань останутся в ране и спровоцируют осложнения.
Врач направит на анализы для полноценной оценки состояния здоровья. Затем он подберет лечение, которое обычно состоит из таких процедур:
- прием антибиотиков;
- устранение причины воспаления;
- соблюдение диеты;
- иммунотерапия.
Антибиотики при фурункулезе используются для уничтожения бактерий (стафилококка), чаще всего назначаются препараты с широким спектром эффективности, а именно Амоксициллин, Метициллин, Оксациллин.
Если чирей не может вскрыться самостоятельно или фурункулы множественные, тогда следует пойти к хирургу, который правильно вскроет и качественно прочистит гнойничок.
Профилактика заражения и рецидивов
Для профилактики заражения стафилококком нужно просто соблюдать гигиену: мыть руки после контакта с людьми, у которых есть признаки фурункулеза, и поверхностями в общественных местах, мыть остальные части тела регулярно, следить за чистотой одежды, убирать в жилых и рабочих помещениях. Чтобы не столкнуться с заболеванием, нужно:
- вести активный здоровый образ жизни;
- снижать чрезмерный вес;
- употреблять здоровую пищу (чем больше количество витаминов, тем лучше);
- укреплять иммунитет;
- отказаться от мучного и вредных привычек;
- проводить своевременное лечение хронических заболеваний;
- контролировать уровень сахара в крови.
Не стоит бояться всего вокруг в надежде не подцепить стафилококк, нужно просто следить за своим здоровьем и соблюдать базовые правила личной гигиены. Тогда никакие заболевания, в том числе фурункулез, не побеспокоят.